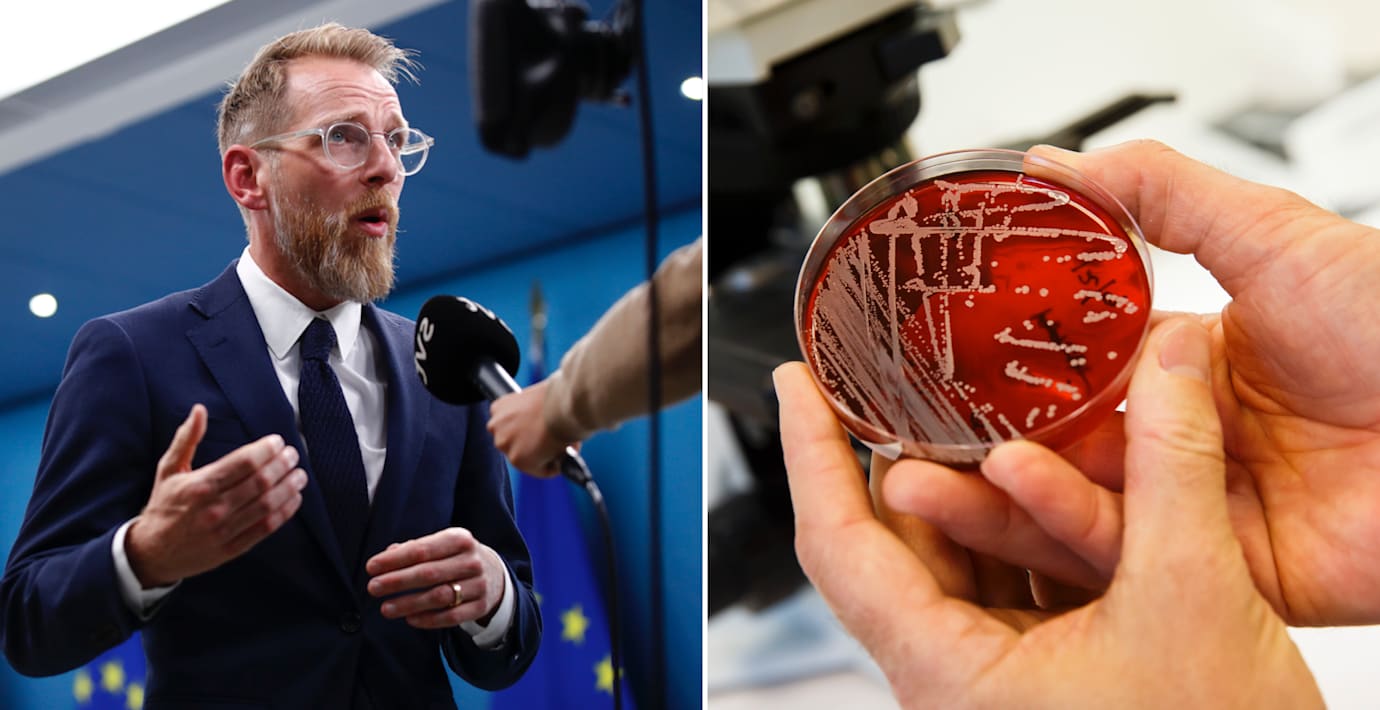

Forssmed: Allvarligt läge med penicillinbrist
Bristen på penicillin i Sverige och i EU förväntas förvärras under hösten och det pågår just nu ett intensivt arbete för att säkra upp kritiska mediciner som antibiotika, rapporterar Ekot.
Socialminister Jakob Forssmed (KD) menar att läget är allvarligt.
– Regeringen har fattat flera beslut för att säkra tillgången till antibiotika, både ny men också äldre antibiotika, som är så viktig för att vi inte ska utveckla mer resistens för då får vi också stora problem i framtiden.
Kriget i Ukraina uppges vara en av orsakerna bakom läkemedelsbristen internationellt. Den svaga svenska kronan har även gjort att flera läkemedelsföretag inte prioriterar den svenska marknaden.
Omni är politiskt obundna och oberoende. Vi strävar efter att ge fler perspektiv på nyheterna. Har du frågor eller synpunkter kring vår rapportering? Kontakta redaktionen



